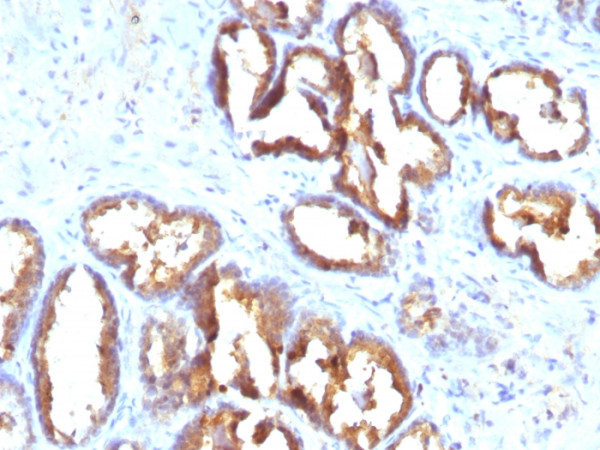
Anti-Prostate Specific Acid Phosphatase (PSAP), clone PASE/4LJ

Cookie preferences
This website uses cookies, which are necessary for the technical operation of the website and are always set. Other cookies, which increase the comfort when using this website, are used for direct advertising or to facilitate interaction with other websites and social networks, are only set with your consent.
Configuration
Technically required
These cookies are necessary for the basic functions of the shop.
"Allow all cookies" cookie
"Decline all cookies" cookie
CSRF token
Cookie preferences
Currency change
Customer-specific caching
FACT-Finder tracking
Individual prices
Selected shop
Session
Comfort functions
These cookies are used to make the shopping experience even more appealing, for example for the recognition of the visitor.
Note
Show the facebook fanpage in the right blod sidebar
Statistics & Tracking
Affiliate program
Conversion and usertracking via Google Tag Manager
Track device being used
| Item number | Size | Datasheet | Manual | SDS | Delivery time | Quantity | Price |
|---|---|---|---|---|---|---|---|
| NEO-55-MSM3-P1ABX | 100 µg | - | - |
Request delivery time estimate |
704.00€
|
If you have any questions, please use our Contact Form.
You can also order by e-mail: info@biomol.com
Larger quantity required? Request bulk
You can also order by e-mail: info@biomol.com
Larger quantity required? Request bulk
Formulation: Purified Ab WITHOUT BSA and Azide at 1.0mg/ml. Cellular Localization: Cell membrane,... more
Product information "Anti-Prostate Specific Acid Phosphatase (PSAP), clone PASE/4LJ"
Formulation: Purified Ab WITHOUT BSA and Azide at 1.0mg/ml. Cellular Localization: Cell membrane, Cytoplasm, Cytosol, Lysosome membrane, Nucleus, Secreted. Positive Control: PC12 cells. Normal prostate or prostate carcinoma. Chromosome Location: 3q22.1. Protein Function: A non-specific tyrosine phosphatase that dephosphorylates a diverse number of substrates under acidic conditions (pH 4-6) including alkyl, aryl, and acyl orthophosphate monoesters and phosphorylated proteins (PubMed:10506173, PubMed:15280042, PubMed:20498373, PubMed:9584846). Has lipid phosphatase activity and inactivates lysophosphatidic acid in seminal plasma (PubMed:10506173, PubMed:15280042) , Tyrosine phosphatase that acts as a tumor suppressor of prostate cancer through dephosphorylation of ERBB2 and deactivation of MAPK-mediated signaling (PubMed:20498373). In addition to its tyrosine phosphatase activity has ecto-5'-nucleotidase activity in dorsal root ganglion (DRG) neurons. Generates adenosine from AMP which acts as a pain suppressor (By similarity) , (Microbial infection) Forms amyloid beta-sheet fibrils in semen. These fibrils, termed SEVI (semen-derived enhancer of viral infection) capture HIV virions, attach them to target cells and enhance infection (PubMed:18083097, PubMed:19451623, PubMed:19897482). SEVI amyloid fibrils are degraded by polyphenol epigallocatechin-3-gallate (EGCG), a constituent of green tea (PubMed:19451623). Target cell attachment and enhancement of HIV infection is inhibited by surfen (PubMed:19897482). Also similarly boosts XMRV (xenotropic murine leukemia virus-related virus) infection (PubMed:19403677) [The Uniprot Consortium]
| Keywords: | Anti-ACP3, Anti-5'-nucleotidase, Anti-Acid phosphatase 3, Anti-Ecto-5'-nucleotidase, Anti-Thiamine monophosphatase, Anti-Prostatic acid phosphatase, Anti-Protein tyrosine phosphatase ACP3, 559 |
| Supplier: | NeoBiotechnologies |
| Supplier-Nr: | 55-MSM3ABX |
Properties
| Application: | IHC |
| Antibody Type: | Monoclonal |
| Clone: | PASE/4LJ |
| Conjugate: | No |
| Host: | Mouse |
| Species reactivity: | human |
| MW: | 52 kD |
| Format: | Purified |
Database Information
| KEGG ID : | K19283 | Matching products |
| UniProt ID : | P15309 | Matching products |
| Gene ID : | GeneID 55 | Matching products |
Handling & Safety
| Storage: | -20°C |
| Shipping: | +4°C (International: +4°C) |
Caution
Our products are for laboratory research use only: Not for administration to humans!
Our products are for laboratory research use only: Not for administration to humans!
You will get a certificate here
Viewed